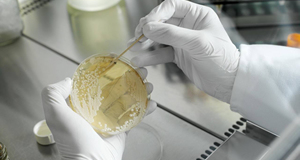

╔Ņś╦īŹ“×╩ꯩ╔Ņ█┌Ż®ėąŽ▐╣½╦Š
Shenzhen standard laboratory (Shenzhen) Co., Ltd
╔Ņś╦īŹ“×╩ꯩ╔Ņ█┌Ż®ėąŽ▐╣½╦ŠŻ©SLTŻ®╩Ūć°╝ęĖ▀ą┬╝╝ągŲ¾śIŻ©ŠÄ╠¢Ż║GR202444206680)Īó┐Ų╝╝ą═ųąąĪŲ¾śIĪŻĮøÅV¢|╩Ī╩ął÷▒OČĮ╣▄└ĒŠųšJūC▓ó╚ĪĄ├Öz“×Öz£yÖCśŗ┘Y┘|Ż©CMAŻ®Ą─ę╗╝ę¬Ü┴óĪóīŻśIĄ─Ą┌╚²ĘĮÖz£yÖCśŗĪŻų┬┴”ė┌×ķ┐═æ¶╠ß╣®ś╦£╩ĪóīŻśIĪóĖ▀ą¦Īóā×┘|Ą─Öz“×Öz£yĘ■äšĪŻę└ššRB/T214-2017╝░ISO/IEC:17025-2017ś╦£╩¾wŽĄĮ©┴óś╦£╩╗»Īó¼F┤·╗»Ą─īŹ“×╩ęŻ¼×ķ╔ńĢ■Ė„Įń╠ß╣®ŽÓĻP╝╝ągū╔įāĪóŁhŠ│Öz£yĪó╝ū╚®Öz£yĪó┐šÜŌ┘|┴┐Īó╣ŌĪó┬ĢĪó¤ßŁhŠ│Īó┐šÜŌ╬’└ĒąįĪó╣½╣▓ąl╔·Ą╚Öz“×Öz£yĘ■äšĪŻ
ū„×ķīŻśIĄ─Öz“×Öz£yÖCśŗŻ¼ōĒėąÅ─╩┬ŁhŠ│Öz£yŅIė“Ą─īŻśIłFĻĀŻ¼ æ{ĮĶą█║±Ą─┐ŲčąĪó╝╝ąg║═╚╦▓┼┘Yį┤Ż¼Ž╚▀MĄ─āxŲ„įOéõŻ¼├µŽ“╔ńĢ■│ąĮėŁhŠ│Öz£yĪó╝ū╚®Öz£yĪó┐šÜŌ┘|┴┐Īó╣ŌĪó┬ĢĪó¤ßŁhŠ│Īó┐šÜŌ╬’└ĒąįĪó╣½╣▓ąl╔·Ą╚Öz“×Öz£yĘ■䚯¼×ķ┐═æ¶╠ß╣®Š▀ėąĘ©┬╔ą¦┴”Ą─CMAÖz“׳¾ĖµŻ¼ł¾Ėµ╣½ą┼┴”ÅŖŻ¼īó╩╝ĮK▒Ż│ų┐ŲīWĪóć└ųöĪó╣½ŲĮ......
READ MORE>>
|
|